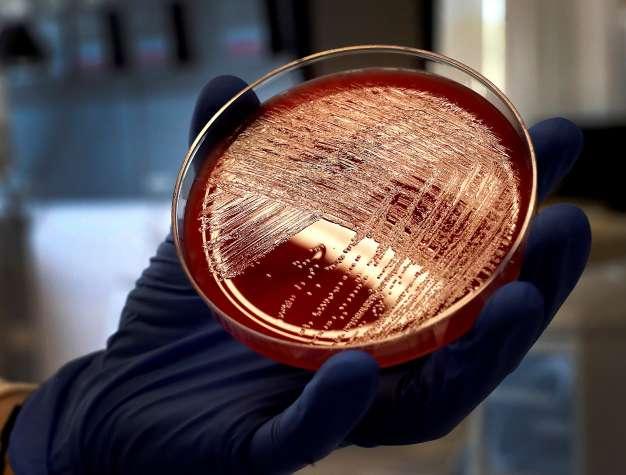

Viernes | 24 de octubre de 2025 West Michigan, Edición 717. Ejemplar gratuito.

El periódico que informa de verdad
![]()
Viernes | 24 de octubre de 2025 West Michigan, Edición 717. Ejemplar gratuito.

El periódico que informa de verdad

La gobernadora Gretchen Whitmer firmó una directiva ejecutiva que ampliará el conocimiento de los programas de vivienda asequible de Michigan para que más jóvenes puedan adquirir una vivienda sin gastar una fortuna. ►P.3
ACLU Michigan anuncia la liberación de inmigrante detenido a pesar de leucemia potencialmente mortal
Por Héctor Loya/DETROIT, MI
La ACLU de Michigan anunció el miércoles de esta semana que después de estar detenido durante más de dos meses, José Contreras-Cervantes fue liberado y se reunió con su familia.
El hombre padece de leucemia potencialmente mortal y había estado detenido en las instalaciones de ICE en el condado de Lake desde el mes de agosto luego de su arresto y con orden de deportación. En este mes ACLU presentó
una petición en el Tribunal de Distrito de Estados Unidos en Detroit, pidiendo a un juez que ordenara audiencias de fianza para Contreras-Cervantes.
La semana pasada la jueza federal de distrito ordenó que los solicitantes recibieran una
audiencia de fianza dentro de siete días o fueran liberados inmediatamente.
A Contreras, un hombre de 33 años y padre de tres hijos que lleva 20 años viviendo en Estados Unidos sin permiso de residencia. ►P.8


n una sociedad que se precia de defender la justicia y los derechos humanos, no hay crimen más atroz ni más doloroso que el abuso de menores. Este delito no solo vulnera el cuerpo de un niño o una niña; hiere su alma, marca su confianza en los adultos y deja cicatrices invisibles que pueden acompañarlo toda la vida.
Lo más indignante es que, en demasiados casos, el abuso ocurre en silencio. El miedo, la vergüenza, el “qué dirán” o la presión social hacen que familias enteras callen, que testigos miren hacia otro lado y que instituciones no actúen con la urgencia que la situación exige. Ese silencio cómplice —consciente o no— es el mejor aliado del abusador.
Cada vez que un caso de abuso infantil sale a la luz, a menudo años después de ocurrido, escuchamos las mismas palabras: “Nadie dijo nada”, “Nadie quiso meterse”. Pero mientras tanto, un menor vivía un infierno. Y cuando finalmente se atreve a hablar,
en muchos casos el agresor ya no está en el país o ha logrado escapar de la justicia.
Como sociedad, no podemos seguir siendo espectadores de este drama. Denunciar el abuso de menores no es una opción moral: es una obligación legal y ética. Las autoridades deben garantizar canales de denuncia seguros y una atención psicológica adecuada a las víctimas. Los medios de comunicación, por su parte, tenemos la responsabilidad de informar con sensibilidad y de visibilizar el problema sin revictimizar.
El silencio protege al agresor. La denuncia protege al niño. Romper ese silencio es un acto de amor y de valentía. Y mientras sigamos guardando silencio por miedo al “qué dirán”, seguiremos siendo cómplices de la impunidad.
Ha llegado el momento de hablar, actuar y proteger lo más sagrado que tiene toda sociedad: su infancia.


2000 28th ST SW, WYOMING, MI. 49509
GENERAL DIRECTOR
Luis E. Molina
EDITORIAL
DIRECTOR
Hector Loya
REPORTERS
Eric Padilla
SPORTS
Editorial Staff
EDITORIAL DESIGN
Jonatán Polanco
WEB PAGE
Mel Polanco
VIDEO
PRODUCTIONS
Edgar Castro Edelí Cota
Carmen Gudiño
ACCOUNTING
Alma Molina
DISTRIBUTION
Juliana Rodríguez
Junior Rodríguez
Fredy Granillo
Jorge Molina
Abel Castañeda
COLLECTION AGENT
Nick Monarrez
CONTRIBUTORS
Maria Saucedo
Melisa Utz
The rights to this publication belong to El Informador and are protected by the universal copyright convention. It is illegal to reproduce text, advertisements,photos, or articles by any printed,electronic, radio, or digital media without El Informador’s permission in writing.
At El Informador we strive to respectand maintain the freedom of expressionand the right of every thought and opinion in every article of our contributorsand advertisers, but that does not meanthat we are in all accordance with their concepts and opinions in said articlesand information of each advertiser.
Opinión por Héctor Loya
Los héroes nos inspiran, nos motivan y nos ayudan a creer que cualquier cosa es posible. Igualmente, nos hacen ver formas de enfrentarnos a retos que nos presenta la vida y nos inculcan valores y virtudes importantes como la fortaleza, la amistad y la perseverancia.
Pero no estoy hablando únicamente de los héroes de los cuentos o de los mitos. Hablo de héroes cotidianos, de padres, de educadores, de gente en la calle que ayuda a los demás, de gente real que inspira a los demás.
Además de los héroes de la ficción, hay una infinidad de modelos de héroes reales que nos sirven de ejemplo a la hora de vivir nuestras vidas. Los héroes están presentes en las comunidades, en el día a día. Héroes cuyos oficios o acciones tienen un impacto real entre quienes los rodean.
Existen hombres y mujeres de verdad que transforman el lugar que habitamos. Sin capa, sin máscara, ni súper poderes. Todos debemos incorporar estos héroes cotidianos a nuestras vidas. No solo servirán para inspirar con el ejemplo e ilustrar, sino que puede enseñar cómo podemos sobrellevar los retos que plantea la vida real.
Aparte de los héroes de los cómics, dibujos animados y cuentos, todos necesitamos héroes cercanos para sobrevivir y aprender a cultivar una autoestima saludable, gente capaz de hacernos sentir que también podemos ser héroes. Necesitamos quienes nos ayuden, sin importar la edad, a razonar pero también a guiarse por intuición e instinto.
Personas cercanas que nos inspiren a llevar a cabo sueños y nos ofrezcan modelos a seguir. Hoy día, deportistas, estrellas del rock o pop y actores son confundidos con héroes cuando en realidad son atletas y personas con mucho talento, pero no son héroes.
Los héroes son como lo mencioné antes nuestros padres, nuestras madres, familiares, buenos amigos Vecinos y a veces hasta desconocidos que están dispuestos a ayudar.

Por Héctor Loya/LANSING, MI
La gobernadora Gretchen Whitmer firmó una directiva ejecutiva que ampliará el conocimiento de los programas de vivienda asequible de Michigan para que más jóvenes puedan adquirir una vivienda sin gastar una fortuna. Desde que asumió el cargo, la gobernadora Whitmer también ha incrementado la oferta de vivienda asequible mediante el establecimiento de múltiples programas históricos que brindan estabilidad social y económica, fortalecen la fuerza laboral de Michigan y reducen los costos para todos los michiganeses. Sin embargo, muchos michiganeses, especialmente los jóvenes, desconocen estos programas o desconocen si cumplen los requisitos. La administración Whitmer-Gilchrist se compromete a garantizar que todos tengan un lugar seguro y asequible donde vivir y con-

tinuará realizando inversiones récord para construir o rehabilitar viviendas, como lo ha hecho durante los últimos siete años.
“Estoy orgullosa del trabajo que hemos realizado para ampliar la vivienda asequible para todas las familias de Michigan”, dijo la gobernadora Whitmer . “Estos programas permiten que más personas compren la casa de sus sueños, una primera vivienda o alquilen un excelente apartamento en una comunidad próspera. Hemos avanzado mucho, pero necesitamos que más habitantes de Michigan, especialmente nuestros jóvenes, aprovechen los programas que ofrece nuestro estado. Esta directiva ejecutiva ayudará a que más habitantes de Michigan conozcan y utilicen los programas de vivienda asequible que hemos trabajado arduamente para establecer. Seguiré trabajando con quienes nos ayuden a ayu-
dar a más familias a triunfar en Michigan”.
La gobernadora Whitmer ha ordenado a la Autoridad de Desarrollo de Vivienda del Estado de Michigan (MSHDA) que aumente su difusión mediante la revisión de su estrategia de marketing y comunicación en relación con los programas que buscan reducir las barreras para la propiedad de vivienda y el alquiler asequible. La MSHDA ofrece numerosos programas que los residentes de Michigan pueden utilizar para comprar su primera vivienda o pagar el alquiler. Sin embargo, a menudo las personas desconocen que son elegibles para estos programas o que no conocen su existencia.
La MSHDA debe trabajar para llegar a las comunidades con niveles desproporcionadamente bajos de propiedad de vivienda o acceso a viviendas de alquiler asequibles. ►P.11







Por Edgar Castro/GRAND RAPIDS, MI
Las reglas de estacionamiento estacionales entrarán en vigor este sábado 1.º de noviembre en muchas calles residenciales de la ciudad. Estas restricciones permiten que los equipos municipales limpien eficientemente hojas, ramas y nieve, y aseguran el acceso para vehículos de emergencia durante el otoño e invierno.
Según el Departamento de Obras Públicas, las restricciones aplican con o sin nieve en el suelo, y estarán vigentes hasta el 1.º de abril. “Pedimos la colaboración de los residentes para mantener las calles limpias y prevenir posibles inundaciones en invierno”, señaló John Gorney, director de Obras Públicas de la ciudad.
¿CÓMO FUNCIONAN LAS RESTRICCIONES?
Las calles afectadas están claramente señalizadas. Existen dos tipos de reglas:
1. Estacionamiento alternado (pares e impares)
• Días pares (2, 4, 6, etc.): Prohibido estacionar en el lado impar de la calle, entre la 1:00 a.m. y 6:00 p.m.
• Días impares (1, 3, 5, etc.): Prohibido estacionar en el lado par, en el mismo horario.
• Entre las 6:00 p.m. y la 1:00 a.m., se permite estacionar en ambos lados, a menos que haya señales que digan lo contrario.
2. Estacionamiento en un solo lado En algunas calles más estrechas, solo se permite estacionar
en un lado designado durante toda la temporada. En ciertos casos, no se permite estacionar en absoluto. Los vehículos que no respeten estas reglas podrán recibir una multa de $20, incluso si no ha nevado. Las autoridades recomiendan prestar atención a las señales de tránsito para evitar sanciones. Los residentes pueden reportar vehículos mal estacionados por estas vías:
• Aplicación “grcity 311” (iOS y Android)
• Página web: grandrapidsmi.gov (sección “Report a Parking Complaint”)
• Llamando al 311 o al 616456-3000
Para ver un mapa interactivo con las calles afectadas por estas reglas, los residentes pueden visitar el sitio oficial de la ciudad.







Edgar Castro/DETROIT, MI
La Unión Americana de Libertades Civiles (ACLU, por sus siglas en inglés) celebró este viernes una decisión judicial que ordena al gobierno federal liberar de inmediato a diez inmigrantes detenidos —incluidos ocho residentes de Michigan— o, en su defecto, realizar audiencias de fianza en un plazo máximo de siete días.
Entre los beneficiarios se encuentra José Contreras-Cervantes, un padre de familia con tres hijos ciudadanos estadounidenses y residente de Michigan desde hace años. José sufre de leucemia, y su tratamiento se ha visto gravemente afectado por su detención desde principios de agosto.
“Esta decisión judicial devuelve la esperanza a familias que han sido separadas injustamente”, dijo Miriam Aukerman, abogada principal de la ACLU de Michigan. “Si ICE no se detiene, nosotros tampoco lo haremos”.
LA RAÍZ DEL PROBLEMA
El caso gira en torno a una directiva emitida por la administración Trump en julio, que niega a ciertos inmigrantes el derecho a una audiencia de fianza, a pesar de que la ley de inmigración permite ese proceso. La ACLU argumentó que esta política es inconstitucional y viola décadas de práctica legal.
En su fallo, la jueza federal Brandy R. McMillion coincidió con la ACLU, declarando que los inmigrantes como Contreras-Cervantes tienen derecho a ser liberados mientras enfrentan sus casos migratorios, especialmente si han vivido en EE.UU. durante años y tienen vínculos familiares fuertes.
“El derecho más elemental es estar libre de detención física injustificada”, escribió la jueza McMillion. “No podemos escoger qué leyes cumplir solo cuando nos conviene”.
FAMILIAS AFECTADAS EN TODO EL ESTADO
Además de Contreras-Cervan-
◄ La ACLU celebra fallo que beneficia a familias migrantes en Michigan (Foto vía PY).
tes, otros siete clientes representados por la ACLU y dos personas representadas por abogados privados se beneficiarán de esta decisión. En agosto, un caso similar permitió la liberación de Juan Manuel López-Campos, padre de cinco hijos ciudadanos estadounidenses y residente de Detroit.
EL IMPACTO HUMANO
Lupita Contreras-Cervantes, esposa de José, expresó su alivio tras conocer el fallo:
“Este fallo nos devuelve la esperanza. La salud de José está en riesgo y mis hijos sufren por estar lejos de su padre. Tuvimos que celebrar tres cumpleaños sin él. Ahora solo queremos tenerlo de nuevo en casa”.
La ACLU subrayó que estos casos no son aislados. Decenas de cortes federales en todo el país han fallado en contra de esta política migratoria, permitiendo que los inmigrantes tengan al menos el derecho básico a una audiencia.


Los senadores republicanos fracasaron por duodécima ocasión en un intento de votación para aprobar un plan de financiamiento provisional que ponga fin al actual cierre del Gobierno federal, el cual se ha convertido en el segundo más largo de la historia estadounidense tras superar los 22 días.
Los demócratas del Senado lograron bloquear nuevamente el proyecto de ley republicano, que terminó con 54 votos a favor y 46 en contra, de los 60 que se necesitan legalmente para aprobarlo.
En esta ocasión, tres congresistas de oposición votaron junto a los republicanos: Catherine Cortez Masto, John Fetterman y el independiente Angus King.
La votación se retrasó debido a un discurso maratónico del senador Jeff Merkley (demócrata de Oregón), quien

Imagen de archivo del senador demócrata por el estado de Oregón, Jeff Merkley. EFE/NYEIN CHAN NAING
mantuvo la palabra durante 22 horas y 39 minutos.
Durante su intervención, Merkley criticó las políticas de Trump, incluyendo la persecución de opositores políticos y el despliegue del ejército en ciudades gobernadas por demócratas. También denunció lo que consideraba una
estrategia para beneficiar a los ricos a expensas de las familias estadounidenses.
Por parte de los republicanos, el senador Rand Paul votó en contra de aprobar la medida, y el líder republicano del Senado, John Thune, cambió su voto a “no” al final, una medida de procedimiento que

le permitirá volver a plantearla en el futuro.
El cierre del Gobierno alcanzará los 23 días este jueves, convirtiéndose en el segundo más largo de la historia, solo por detrás del que duró 35 días, entre el 22 de diciembre de 2018 y el 25 de enero de 2019, durante la primera administración de Trump.
Al final de esta semana, más de 1,3 millones de trabajadores afectados por el cierre dejarán de percibir el pago de su quincena por primera vez desde que el gobierno federal quedó paralizado.
La falta de acuerdos entre ambos partidos se debe a que los demócratas insisten en mantener los subsidios de Obamacare, el programa de seguro de salud que beneficia a millones de estadounidenses, mientras que los republicanos buscan dejarlo fuera, alegando, sin pruebas, que beneficia a inmigrantes ilegales.
VIENE DE PORTADA
Le diagnosticaron el año pasado leucemia mieloide crónica, un cáncer de médula ósea potencialmente mortal.
Según su abogado, el hispano fue arrestado en una parada de tráfico el 5 de agosto en el condado de Macomb, cerca de Detroit, no tenía antecedentes penales más allá de infracciones de tráfico menores.
El abogado también dijo que las autoridades federales se negaron a liberarlo, a pesar de su leucemia y la atención médica inconsistente que había recibido mientras estaba detenido.
ACLU solicitó una audiencia de fianza para Contreras-Cervantes, que le permitiría regresar con su familia y sus médicos del área de Detroit mientras su caso avanzaba en la corte de inmigración.

◄ José Contreras Cervantes, inmigrante enfermo de leucemia detenido por ICE y que fue liberado y se reunió con su familia.
(Foto: Cortesía de ACLU)




Por Edgar Castro/GRAND RAPIDS, MI
La creciente popularidad de las bicicletas eléctricas en East Grand Rapids ha generado preocupación entre los residentes por los riesgos asociados a su uso. Estos vehículos, que alcanzan velocidades de hasta 45 km/h, están aumentando la preocupación por la seguridad tanto de ciclistas como de peatones.
precauciones necesarias para garantizar su seguridad y la de los demás.


Recientemente, varios incidentes han puesto en evidencia los peligros de la falta de control y supervisión, especialmente entre los más jóvenes. Muchos ciclistas circulan sin casco, y en algunos casos, sin tomar las

La ciudad ha comenzado a tomar medidas para abordar estos problemas. Se están promoviendo programas educativos para enseñar a los niños sobre la seguridad vial y el uso adecuado de bicicletas eléctricas y otros vehículos similares. Además, se está trabajando en la expansión de carriles para bicicletas y en la evaluación de nuevas normativas para mejorar la seguridad en las calles.
En el marco de las festividades de Halloween, la ciudad distribuirá equipo reflectante para ciclistas y promoverá el
uso de luces para mejorar la visibilidad. Estas acciones forman parte de un esfuerzo más amplio para asegurar que todos los usuarios de la vía pública, ya sean ciclistas o peatones, puedan desplazarse con mayor seguridad. Con el creciente uso de bicicletas eléctricas, las autoridades locales subrayan la importancia de la cooperación de la comunidad en el cumplimiento de las normas de seguridad y en la educación sobre el comportamiento responsable en las vías. La seguridad vial se ha convertido en una prioridad para garantizar el bienestar de todos en East Grand Rapids.

Madrid/Miami, EFE
Un centenar de personalidades del mundo hispano, procedentes de la política, la ciencia, el arte, el activismo o la comunicación conforman la lista “Los 100 latinos más comprometidos con la acción climática 2025”, impulsada por la organización Sachamama para reconocer la labor de quienes fomentan la acción ambiental climática.
Alexandria Ocasio-Cortez, Eva Longoria, Carlos Vives, Claudia Sheinbaum, Luiz Inácio Lula da Silva o Macaco son algunos de los nombres en el listado de líderes que impulsan políticas sostenibles, visibilizan la emergencia climática o promueven modelos económicos bajos en carbono, han destacado desde la ong Sachamama, impulsora de la iniciativa que, un año más, cuenta con el apoyo de Agencia EFE.
"Cada persona reconocida incluida en la lista 2025 representa una historia de visión, resiliencia y compromiso, demostrando que la transición justa y sostenible ya está en marcha; estos líderes reflejan los esfuerzos transversales que se avanzan desde diferentes sectores y cómo, a través de la colaboración, aceleraremos la acción climática por lo que esperamos seguir trabajando de la mano para potenciar las historias y soluciones de cada uno de ellos", dijo Carlos Zegarra, director ejecutivo de Sachamama.
"Los 100 latinos son hombres y mujeres que, con sus acciones, nos están mostrando el camino para actuar frente a la emergencia climática y combatir la creciente desinformación socioambiental a la que cada día nos enfrenta-

mos y que desde el periodismo combatimos", ha expresado el presidente de EFE y miembro del jurado internacional, Miguel Ángel Oliver.
ESTADOS UNIDOS, COLOMBIA Y MÉXICO
Estados Unidos encabeza la lista, con 18 representantes, entre ellos la congresista Ocasio-Cortez, la actriz America Ferrera, la activista Leila Salazar López (Amazon Watch) o el presidente de GreenLatinos, Mark Magaña.
Le siguen Colombia (13), con figuras como el biólogo Fernando Trujillo, la relatora de la ONU Astrid Puentes o el músico Carlos Vives, y México (12), representado por la presidenta Claudia Sheinbaum, la exsecretaria de la ONU sobre Cambio Climático Patricia Espinosa, la fotógrafa Cristina Mittermeier o el caricaturista Víctor Solís (@visoor).
También destacan Ecuador (11), con la activista Helena Gualinga y la líder indígena
Nemonte Nenquimo, y Brasil (10), con el presidente Lula da Silva, la ministra Sônia Guajajara y la científica Natalie Unterstell.
Chile (8), España (6), Costa Rica (5), y Perú (5) completan el listado, junto a representantes de Argentina, Venezuela, Cuba y Puerto Rico.
MUJERES AL FRENTE DE LA ACCIÓN CLIMÁTICA
De los 100 nombres, 58 son mujeres, lo que refleja la creciente presencia femenina en la acción ambiental y climática. Entre ellas, Christiana Figueres, artífice del Acuerdo de París; Marina Silva, ministra brasileña de Medio Ambiente; Celeste Saulo, secretaria general de la Organización Meteorológica Mundial, o Julia Carabias, referente de la ecología en México.
En el ámbito empresarial y científico figuran líderes como Gonzalo Muñoz (Chile), campeón climático de la ONU, y Manuel Pulgar-Vidal
(Perú), de WWF y exministro de Medio Ambiente.
Desde el periodismo y la comunicación, Javier Peña (Hope), Arturo Larena, director de EFEverde.com, y la periodista argentina Tais Gadea Lara, aportan la perspectiva mediática de la sostenibilidad.
DIVERSIDAD DE ÁMBITOS Y UN MENSAJE COMÚN
La lista de Sachamama combina políticos, científicos, artistas, comunicadores y activistas que, desde distintos frentes, trabajan por un mismo objetivo: acelerar la transición hacia economías bajas en carbono y proteger la biodiversidad.
Más allá del reconocimiento individual, la organización subraya que este listado pretende "fortalecer la voz colectiva del mundo hispano en la acción climática global", un desafío que hoy une a comunidades desde el Amazonas hasta Nueva York o Madrid.
Por Edgar Castro/JAMESTOWN, MI
Una niña de 13 años permanece hospitalizada con heridas graves luego de ser atropellada por un automóvil la tarde del jueves en el condado de Ottawa, según informó la Oficina del Sheriff del Condado de Ottawa.
El accidente ocurrió alrededor de las 3:00 p.m. en la intersección de la Avenida 24 y la calle Riley. De acuerdo con la investigación preliminar, una mujer de 35 años, residente de Wyoming (MI), conducía un Honda Civic 2015 hacia el norte por la Avenida 24 y
se detuvo en la señal de alto antes de la calle Riley. En ese momento, la menor cruzaba la calle por el cruce peatonal, y el vehículo la golpeó al reanudar la marcha. La conductora no resultó herida, mientras que la adolescente fue trasladada a un hospital
de la zona para recibir atención médica. Las autoridades no han revelado su identidad debido a su edad. La Oficina del Sheriff continúa investigando las circunstancias del accidente para determinar si hubo negligencia o distracción por parte de la conductora.




Por Héctor Loya/KALAMAZOO, MI
Mientras se sigue celebrando el mes de la herencia hispana en todo el estado de Michigan el Departamento de Policía de Kalamazoo dice estar orgulloso de contar con el sargento Fidel Mireles, miembro hispano del corporativo.
Cuando se le preguntó al sargento Mireles cómo su herencia ha moldeado quién es o cómo sirve con el KDPS, el oficial compartió lo siguiente:
"Mi herencia me ha formado para mantenerme castigado y humilde, sin importar mi posición. Fui criado para tratar a todos con respeto y reconocer el valor de cada persona. Eso se lleva a la forma en que sirvo y lidero en KDPS. Incluso como supervisor, nunca olvido que soy parte de un equipo y que cada papel, desde el nuevo
VIENE DE LA PÁGINA 3
Como los residentes de Michigan de 18 a 35 años, garantizando que los residentes de estas comunidades conozcan y tengan acceso a los programas disponibles para aumentar su participación. También se instruye a otros departamentos a colaborar con la MSHDA para apoyar la vivienda asequible en nuestro estado.
La gobernadora Whitmer ha realizado importantes inversiones en vivienda asequible, creando numerosas iniciativas para aumentar la oferta de viviendas asequibles y reducir los costos de la vivienda. En 2021, creó el primer plan estatal de vivienda de Michigan, que estableció el objetivo de construir o rehabilitar 75,000 viviendas en cinco años. Tras alcanzar el objetivo original en agosto de este año, la gobernadora Whitmer lo elevó a 115,000 unidades.
La gobernadora Whitmer también ha realizado inversiones récord para ampliar el acceso a la vivienda en Michigan. En 2023, invirtió $1.23 mil millones en la construcción y preservación de viviendas asequibles. En 2024, esa inversión casi se duplicó, alcanzando los $2.16 mil millones. Además de aumentar la oferta, la gobernadora Whitmer ha establecido programas para reducir los costos para los compradores de vivienda. En 2023, los programas de propiedad de vivienda de la MSHDA invirtieron $608 millones, apoyando a 4.402 com-
recluta hasta el oficial de mayor rango, importa. Mi origen me mantiene concentrado en servir a los demás primero y liderar con empatía, no con ego”.
Cuando se le preguntó qué tradición, valor o lección de su familia de la que está más orgulloso, dijo:
"El valor del que más me siento orgulloso de mi familia es la creencia en celebrar hoy, no importa lo malo que parezca. Crecí en un hogar donde, incluso después de un día duro, todavía encontraríamos algo pequeño por lo que estar agradecidos, ya sea compartiendo una comida juntos o simplemente riéndonos al final de la noche. Eso me enseñó que vale la pena reconocer cada día porque es otra oportunidad para hacer las cosas mejor que ayer. En
pradores de vivienda. En 2024, esa inversión aumentó a $772 millones, apoyando a 5.082 compradores de vivienda. El año pasado, la gobernadora Whitmer lanzó el Programa de Alivio de Tasas de la MSHDA, con un presupuesto de $50 millones, para reducir las tasas de interés hipotecarias hasta en un punto porcentual para quienes compran por primera vez. El estado también ha desarrollado programas que ofrecen hasta $10,000 en asistencia para el pago inicial y ahorran a los compradores miles de dólares en impuestos federales. En febrero de 2025, el Programa de Asistencia para el Pago Inicial para Primeras Generaciones, con un presupuesto de $12 millones, comenzó a ofrecer a quienes compran por primera vez, incluso de primera generación, hasta $25,000 en asistencia para el pago inicial. Tanto el Programa de Alivio de Tasas como el Programa de Asistencia para el Pago Inicial para Primeras Generaciones

(Foto: Departamento de Seguridad Pública de Kalamazoo)
seguridad pública, a menudo nos encontramos con gente en sus días más difíciles, y esa perspectiva me ayuda a mantenerme positivo, compasivo, y recordar a los demás que el mañana siempre puede ser diferente”.
Cuando se le preguntó acerca de un modelo a seguir

Whitmer mientras firmaba una directiva ejecutiva que ampliará el conocimiento de los programas de vivienda asequible de Michigan para los jóvenes. (Foto: Oficina Ejecutiva de la Gobernadora)
se agotaron rápidamente, lo que subraya la necesidad de una mayor inversión estatal en programas de acceso a la vivienda.
Este año, la MSHDA prevé invertir más de mil millones de dólares en sus programas de vivienda. El estado se ha fijado el objetivo de respaldar hipotecas en los 83 condados este año y espera alcanzarlo en las próximas semanas. Los programas de propiedad de
hispano o latino que lo inspira, el sargento Mireles compartió: "Mis mayores modelos hispanos a seguir son mis padres. Vinieron de casi nada más que fe, determinación y la esperanza de darnos una vida mejor. Se enfrentaron a barreras económicas, largas horas de trabajo y momentos de incertidumbre, pero nunca perdieron su orgullo por quiénes eran o de dónde venían. Me enseñaron que nuestra cultura se basa en el trabajo duro, la humildad y la gratitud. Verlos crear oportunidades a partir de la lucha me mostró el verdadero significado de la resistencia y la familia. Su fuerza me impulsa a servir a mi comunidad con el mismo corazón y dedicación—para honrar los sacrificios que hicieron y la herencia que me moldeó”.
vivienda de MSHDA ofrecen hipotecas con tasas de interés competitivas, conexiones con educación y asesoramiento para compradores de vivienda y hasta $10,000 en asistencia para el pago inicial.
El objetivo del estado es que todos en Michigan puedan costear un hogar de calidad que satisfaga sus necesidades, en la comunidad de su elección. Ser propietario de una vivienda es una poderosa herramienta para que las familias se integren a la clase media, generen riqueza y participen del sueño americano. Aumentar las oportunidades de ser propietario de una vivienda ayuda a estabilizar los vecindarios, fortaleciendo las comunidades.
Los compradores de vivienda interesados pueden buscar un prestamista participante experimentado para comenzar a explorar una hipoteca MSHDA o comunicarse con MSHDA en MSHDAHomeOwnershipPF@michigan. gov.
“Estoy orgullosa del trabajo que hemos realizado para ampliar la vivienda asequible para todas las familias de Michigan”, dijo la gobernadora Whitmer . “Estos programas permiten que más personas compren la casa de sus sueños, una primera vivienda o alquilen un excelente apartamento en una comunidad próspera. Hemos avanzado mucho, pero necesitamos que más habitantes de Michigan, especialmente nuestros jóvenes, aprovechen los programas que ofrece nuestro estado. Esta directiva ejecutiva ayudará a que más habitantes de Michigan conozcan y utilicen los programas de vivienda asequible que hemos trabajado arduamente para establecer. Seguiré trabajando con quienes nos ayuden a ayudar a más familias a triunfar en Michigan”.
BIENES RAICES

Por Melisa Utz Realtor
¿Puedo vender si todavía debo en la hipoteca?
Una pregunta muy común entre propietarios es: ¿puedo vender mi casa aunque todavía no la haya terminado de pagar? La respuesta es sí, sí puedes vender, incluso si aún debes en la hipoteca.
Hoy en día, es muy normal vender una propiedad antes de terminar de pagarla por completo. Cuando vendes tu casa, el dinero que recibes del comprador se utiliza primero para pagar el saldo pendiente de tu préstamo hipotecario. El resto, si lo hay, es tu ganancia.
Por ejemplo, si vendes tu casa por $250,000 y todavía debes $180,000 al banco, el banco recibirá su pago y tú podrías quedarte con la diferencia, menos los gastos de cierre, comisiones y otros costos relacionados con la venta.
Pero hay algunos puntos importantes a considerar:
• Valor de mercado: Es clave saber cuánto vale tu casa actualmente. Si el valor es menor al saldo de tu hipoteca, podrías estar en una situación de “equity negativa” y necesitarás opciones especiales como una venta corta (short sale).
• Costos de venta: Incluyen comisiones del agente inmobiliario, impuestos, y otros cargos. Asegúrate de calcular bien cuánto recibirás al final.
• Asesoramiento profesional: Un agente de bienes raíces con experiencia puede ayudarte a entender tus números y decidir si es un buen momento para vender.
Vender con una hipoteca no es complicado, pero sí requiere una buena planificación. No dudes en contactarme para una consulta gratis y sin compromiso al 616-644-1685. Síganos en Instagram, Facebook o TikTok en @utz4homes.



Edgar Castro/COVERT TOWNSHIP, MI
Un contratista que realizaba labores en la planta nuclear de Palisades cayó el martes en una cavidad con agua ubicada sobre el reactor de fisión y tuvo que ser sometido a un proceso de descontaminación por posible exposición a radiación.
El incidente fue confirmado por Holtec International, empresa propietaria de la planta, y reportado a la Comisión Reguladora Nuclear de Estados Unidos (NRC). De
acuerdo con Holtec, el trabajador se encontraba dentro del edificio de contención alrededor de las 9:30 de la mañana del 21 de octubre, realizando tareas cerca de una zona húmeda sin barandilla protectora. El contratista portaba el equipo de seguridad requerido, incluido un chaleco salvavidas, pero perdió el equilibrio y cayó al agua.
Compañeros que estaban en el área lograron rescatarlo rápidamente, aunque el trabajador ingirió parte del agua contaminada, según el
informe remitido a la NRC. Tras ser retirado del lugar, el empleado fue descontaminado dentro de las instalaciones, aunque los sensores aún detectaban niveles bajos de radiación. Posteriormente fue trasladado a un centro médico para recibir tratamiento adicional alrededor de las 4:30 p.m.
El suceso ocurrió mientras Holtec continúa con los preparativos para reactivar la planta de Palisades, que permaneció cerrada desde 2022. Si el reinicio se concreta,
sería la primera planta nuclear en Estados Unidos en reabrir después de haber sido clausurada.
El pasado lunes, la instalación había recibido su primer cargamento de combustible nuclear, marcando un paso importante en el proceso de reactivación. Holtec aseguró que las mediciones de radiación están siendo evaluadas y que se espera que la exposición registrada se mantenga dentro de los límites de seguridad establecidos por la normativa federal.
Por Edgar Castro/MUSKEGON, MI
Un incendio registrado durante la madrugada del martes consumió cinco vehículos en el estacionamiento de Ramos Towing, ubicado sobre Getty Street en la ciudad de Muskegon.
De acuerdo con el propietario del negocio, las cámaras de seguridad captaron el momento en que comenzó el fuego, alrededor de las 12:30 a.m. Se detalló que el incendio se originó en un jeep que había sido remolcado al taller después de un accidente ocurrido el domingo. Todo indica que una chispa surgió detrás del faro delantero izquierdo del vehículo, aparentemente provocada por una batería auxiliar que aún conservaba carga eléctrica.
Afortunadamente, no había nadie en el lugar al momento del incidente, y aunque el viento contribuyó a que las llamas se propagaran con rapidez, los bomberos lograron evitar que el fuego alcanzara otras áreas del estacionamiento.
En el operativo participaron unidades del Departamento de Bomberos de Muskegon Heights, del Municipio de Muskegon y de la Ciudad de Muskegon. El Departamento de Bomberos del Municipio de Muskegon confirmó posteriormente que el incendio se debió a una falla eléctrica en la parte delantera del vehículo.

◄ Una falla en un auto genero el incendio y debido al viento se extendió el fuego rápidamente a otras unidades (Foto vía PY).




Por Héctor Loya/OTTAWA, MI
Tras las investigaciones del Departamento de Agricultura y Desarrollo Rural de Míchigan, se detectó influenza aviar altamente patógena en un ave de traspatio. Este es el noveno caso detectado en el condado de Ottawa desde 2022 y el cuarto caso detectado en aves de corral del condado este año. El MDARD está trabajando con socios locales, estatales y federales para responder a los casos de gripe aviar reportados.
La IAAP es un virus contagioso que puede propagarse de diversas maneras a las aves, incluyendo a través de aves silvestres, animales infectados, equipos e incluso la ropa de los cuidadores. Los CDC afirman que el riesgo para la salud pública de la gripe aviar sigue siendo bajo.
Existen medidas clave para prevenir la propagación y la infección de la gripe aviar:

• Prevenir el contacto entre aves domésticas y silvestres
• Lávese las manos antes y después de manipular aves.
• Desinfecte las botas y otros equipos al trasladarse entre gallineros.
• No comparta equipos entre cooperativas u otras granjas.
• Dar a las gallinas agua de pozo o municipal.
• Mantenga el alimento de las aves de corral seguro para garantizar que no haya con-
tacto con animales salvajes. Los dueños y cuidadores de aves deben estar atentos a múltiples muertes repentinas de aves, disminución en la producción de huevos, diarrea o disminución en el consumo de agua. Si sospecha que sus aves podrían tener gripe aviar, llame inmediatamente al MDARD al (800) 292-3939 durante el día o al (517) 3730440 fuera del horario de atención.


Washington, EFE
El secretario de Transporte de Estados Unidos, Sean Duffy, dijo este jueves que no puede descartar cancelaciones o retrasos de vuelos por el actual cierre del Gobierno federal, que ya es el segundo más largo de la historia del país.
"No puedo garantizar que su vuelo vaya a salir a tiempo. No puedo garantizar que su vuelo no vaya a ser cancelado. Dependerá de que nuestros controladores aéreos acudan a trabajar todos los días", declaró Duffy en una rueda de prensa junto al presidente de la Cámara de Representantes, el republicano Mike Johnson.
El cierre del Gobierno, que ya se extiende 23 días sin perspectivas de acuerdo en el Senado, está agudizando la escasez de controladores aéreos en las terminales, que trabajan actualmente sin recibir salarios debido a la paralización de fondos federales y en al-

gunos casos, han comenzado a ausentarse de sus puestos.
Precisamente esta ausencia fue uno de los motivos claves para reabrir el gobierno durante el cierre de 2018-2019, que duró 35 días y es, a día de hoy, el más largo de la historia.
Al igual que otros servicios como la seguridad aeroportuaria y la Seguridad Social, los controladores aéreos son considerados empleados federales esenciales por lo que están obligados a asistir a sus puestos de trabajo a pesar del cierre.
El Senado vota este jueves una propuesta, presentada por el republicano de Wisconsin, Ron Johnson, para usar fondos del Departamento del Tesoro para pagar a estos funcionarios públicos, que deberían recibir sus salarios a partir de este viernes.
La votación, según recogen varios medios, está previsto que fracase porque los legisladores demócratas planean presentar una contramedida que también incluya a los miles de trabajadores, no esenciales, que han sido enviados a sus casas sin cobrar.
Para que cualquiera de las dos propuestas salga adelante se necesitan 60 apoyos, por lo que tanto la estrecha mayoría republicana (53), como los demócratas (45) necesitarán contar con votos de sus oponentes para aprobar las medidas.
Ambas bancadas se culpan de la paralización. Los demócratas presionan por aprobar más financiación para la atención sanitaria del Obamacare, a lo que se oponen los republicanos.
◄ El secretario de Transporte de Estados Unidos, Sean Duffy, Imagen de archivo. EFE/EPA/WILL OLIVER







Nueva York, EFE
Cuatro ciudadanos de Estados Unidos fueron detenidos en la redada de ayer del Servicio de Inmigración y Aduanas (ICE) en Manhattan (Nueva York) que generó protestas de viandantes y activistas, según dijo este miércoles el congresista Dan Goldman.
Goldman, en declaraciones a medios locales en el edificio 26 Federal Plaza, que acoge un centro de detención de ICE, dijo que los cuatro estadounidenses arrestados por los agentes federales pasaron la noche allí y fueron liberados esta tarde sin que se les presentaran cargos.
Según recogen los medios ABC7 y AmNY, Goldman señaló que ICE no tiene permitido detener a ciudadanos del país y que el hecho de que pasaran la noche en detención migratoria sin cargos supone un "abuso de poder".

Los agentes de ICE y otras agencias federales realizaron una redada enfocada en los vendedores ambulantes de falsificaciones, la mayoría africanos, que se suelen situar en la calle Canal del bajo Manhattan, cerca de Chinatown y el Soho, y que se saldó con nueve detenidos. Según el canal Pix11, que cita al Departamento de Seguridad Nacional, los nueve detenidos por ICE ayer son
hombres con "historial criminal" y los cuatro estadounidenses eran "agitadores", pero no está claro si la cifra de detenidos total se refiere solo a inmigrantes o incluye a los ciudadanos.
La fiscal general de Nueva York, Letitia James, creó hoy un portal para que los testigos envíen fotos y videos que documenten las actividades del ICE en el estado para "evaluar cualquier infracción de la ley" y

Nueva York, EFE
Lrecordó que "nadie debe ser sometido a interrogatorios, detenciones ni intimidación ilegales".
Este jueves, grupos activistas proinmigrantes convocaron una protesta contra la actividad de ICE en Nueva York que partió precisamente desde la zona del centro de detención de Federal Plaza y se convirtió en una marcha por las calles cercanas en la que participaban decenas de personas.
íderes políticos, encabezados por la presidenta del Concejo municipal de Nueva York, Adrienne Adams, y religiosos de diversas creencias enviaron este jueves un contundente mensaje al presidente Donald Trump para que mantenga sus manos "fuera de la ciudad", que "no quiere ni necesita una ocupación federal o militar", como ocurre en otras ciudades. "Estamos unidos hoy aquí para exigir a Donald Trump que mantenga sus manos fuera de la ciudad de Nueva York, y para que no interfiera con nuestros vecinos, nuestros hijos y nuestras comunidades", dijo Adams en una rueda de prensa, y destacó que "su administración ha demostrado la voluntad de ignorar la democracia y enviar fuerzas militares contra su propio pueblo".
La advertencia ocurre luego de que el pasado martes unos 40 agentes de inmigración y otras agencias federales se presentaran enmascarados en la ciudad y arrestaran en plena calle a nueve personas en la zona comercial de Canals Street, cerca del popular Barrio Chino y el SoHo, atestada siempre de vendedores ambulantes. La redada sembró el pánico entre los vendedores, que intentaron correr para evitar ser detenidos, así como protestas en la ciudad. Adams, presidenta del Concejo por el Partido Demócrata, insistió en que los agentes de inmigración han violado repetidamente derechos constitucionales,




Washington, EFE
Human Right Watch (HRW) advierte que los agentes del Servicio de Control de Inmigración y Aduanas (ICE) utilizó tácticas violentas desproporcionadas para reprimir protestas en Chicago contra las redadas contra migrantes realizadas en el marco del operativo Midway Blitz bajo el cual más de 1.500 personas han sido detenidas.
En un informe publicado este jueves, HRW indica que "Los agentes federales están usando irritantes químicos y disparando proyectiles contra manifestantes pacíficos, personal médico y periodistas a plena luz del día"
La organización explica que uno de los puntos críticos del uso de la fuerza es que los agentes federales han "simplemente atacado a manifestantes sin provocación previa".
Los abusos descritos por el informe han sido registrados durante manifestaciones surgidas desde mediados de septiembre

en respuesta a la Operación Midway Blitz de Ice, iniciadas el pasado 8 de septiembre, que incrementó las redadas y detenciones en Chicago.
PERSONAS DETENIDAS Y HERIDAS
El informe dice que las entre-
vistas realizadas a doce personas entre manifestantes, personal médico y periodistas presentes se obtuvo testimonios de que los agentes dispararon bolas de pimienta, gas lacrimógeno y otros proyectiles de forma directa, la mayoría de las ocasiones desde
los techos sin una advertencia previa.
Además, se detalla que entre las personas heridas por el uso de este armamento se encuentran personas de movilidad reducida y se menciona el caso de Ashley vaughan, una manifestante que utiliza
un bastón para desplazarse y que recibió un gas pimienta desmayándose en el lugar.
HRW registra la detención de 78 personas, quienes denunciaron haber sido "retenidos" entre 6 a 12 horas y que en repetidas ocasiones los agentes negaron que pudieran ser asistidos por un abogado.
Finalmente, el informe de cuenta de que unos 10 observadores que se encontraban en las jornadas de protesta también fueron heridos, así como periodistas con disparos de gas pimienta en su cuerpo.
PIDEN RENDICIÓN DE CUENTAS
"Las comisiones de supervisión del Congreso sobre el Departamento de Seguridad Nacional (DHS) deberían realizar audiencias públicas", pide
HRW para examinar el uso excesivo de la fuerza por parte de los agentes en el área de Chicago.
Por otra parte, la organización pide que los registros internos de ICE sean revisados
durante citaciones en el Congreso y convocar a "organizaciones independientes de derechos humanos y civiles que presenten testimonios y evidencias".
Durante los últimos dos meses, el Gobierno del presidente, Donald Trump, intensificó sus políticas antimigrantes, movilizando agentes federales en ciudades gobernadas por autoridades demócratas, bajo la justificación de altas cifras de delincuencia pero su enfoque ha sido las redadas contra migrantes.
Esta semana, una corte de apelaciones autorizó a Trump movilizar agentes de la Guardia Nacional hacia Portland bajo el argumento que serán utilizados para "proteger" a los agentes federales que se encuentran realizado operativos en la ciudad.
El mandatario republicano planea extender sus operativos en otras ciudades como San Francisco, la más reciente que mencionó en una de sus ruedas de prensa.




Por Héctor Loya/GRAND RAPIDS, MI
Thomas Shannon, un ex ortodoncista, aceptó declararse culpable en un tribunal federal por cargos de explotación sexual contra una menor.
Según los registros judiciales Shannon dirigía Shannon Orthodontics en las ciudades de Grandville y Plainwell donde era ortodoncista pediatrico. La policía dio a conocer que Shannon fue arrestado después de una larga investigación, donde lograron incautarle material de abuso sexual infantil.
Shannon había salido en agosto de 2025 con una fianza por ese arresto, sin embargo, se presentaron nuevos cargos y fue arrestado bajo nuevos cargos federales. Los documentos
judiciales alegan que Shannon se comunicaba con diferentes menores de edad en línea, pidiéndoles que le enviaran fotos y videos sexualmente explícitos, a veces a cambio de dinero.
La investigación determinó alrededor de 21 víctimas de entre 12 y 17 años afectadas. La mayoría de las comunicaciones tuvieron lugar mientras Shannon estaba en el condado de Kent, mientras que algunas tuvieron lugar mientras estaba en su barco en el condado de Ottawa.
Tras la investigación, las autoridades encontraron numerosos archivos de pornografía infantil explícita en el teléfono de Shannon. De ser encontrado culpable podría enfrentar de 15 a 60 años de

comunicarse con al menos 21 niñas, solicitarles fotos y vídeos explícitos y poseer pornografía infantil. (Foto: Oficina del Sheriff del Condado de Kent)
prisión y una multa de hasta $250,000. Su próxima cita en la corte es el 31 de octubre para una audiencia oficial de cambio de declaración.
Por Héctor Loya/OTTAWA, MI
Un criadero de pavos en el condado de Ottawa fue devorado por las llamas durante la noche del miércoles 22 de octubre.
El Departamento de Bomberos del municipio de Olive informó que el granero, ubicado junto en la Avenida 136 en el municipio de Olive, estaba completamente envuelto en llamas cuando llegaron los servicios de emergencia. El departamento de bomberos
rápidamente desplegó líneas de ataque para combatir el fuego y trabajó con varias agencias vecinas para extinguir el incendio.
El departamento de bomberos de Olive Township compartió fotografías de la escena que muestran el granero destruido.
Hasta el momento no se han revelado las causas del incendio y la pérdida de animales que representó este incendio.

Por Edgar Castro/DALTON, MI
Un niño de 6 años perdió la vida el martes por la tarde tras ser expulsado de un automóvil durante un accidente ocurrido en el condado de Muskegon. De acuerdo con la Oficina del Sheriff del Condado de Muskegon, el accidente se registró alrededor de las 3:40 p.m. en Holton Road, cerca de East Michillinda Road, en Dalton Township.
Las autoridades informaron que un vehículo que
viajaba hacia el sur por Holton Road chocó por detrás a otro auto que circulaba en la misma dirección. El impacto provocó que ambos vehículos invadieran el carril contrario, donde fueron golpeados por un tercer automóvil que venía en sentido norte.
El pequeño, que viajaba como pasajero en el auto del conductor que causó el choque, fue arrojado del vehículo y falleció en el lugar. La Oficina del Sheriff señaló que se sospecha que el alcohol fue
un factor en el accidente, aunque la investigación continúa abierta.
En la escena también participaron el Departamento de Bomberos de Dalton, los Oficiales de Conservación de Michigan, el equipo de Trinity EMS y la Comisión de Carreteras del Condado de Muskegon.
Las autoridades aún no han divulgado la identidad del menor ni de las personas involucradas mientras continúa la investigación.
Miami, EFE
Investigadores de la Universidad de Florida desarrollaron un programa educativo con el objetivo de concienciar sobre la resistencia a los antimicrobianos, considerada una de las principales amenazas sanitarias del siglo por la Organización Mundial de la Salud (OMS).
La resistencia a los antimicrobianos es responsable de 1,27 millones de muertes anuales en todo el mundo, de acuerdo con datos de 2019 de la OMS.
El módulo fue diseñado para alumnos de noveno grado y se centra en explicar qué son las superbacterias, cómo surgen y qué consecuencias tienen para la medicina y la economía globales.
"La educación del consumidor es igual de importante" que el desarrollo de nuevos tratamientos, informó en un comunicado el Instituto de ciencias de los alimentos y
agrícolas de la Universidad de Florida.
El profesor de biología en la escuela de investigación P.K. Yonge y coautor del proyecto, Sanil Nadar, señaló que aunque los antibióticos están presentes en todos los hogares, "la resistencia de los organismos a los medicamentos no está
incluida en el currículo de las escuelas públicas", algo que a su juicio "tiene que cambiar".
"Una de las formas en que se desarrolla la resistencia de estos organismos es a través del uso indebido de antibióticos, como no completar el tratamiento o tratar infecciones virales con antibióticos contra
"Una de las formas en que se desarrolla la resistencia de estos organismos es a través del uso indebido de antibióticos, como no completar el tratamiento o tratar infecciones virales con antibióticos contra los cuales no son efectivos", afirmó Nadar.
mento en el conocimiento de los estudiantes sobre el problema y un mayor interés en la ciencia.
Una de las adolescentes comentó que la materia era "tan genial" que quería dedicarse a ella, destacó el investigador e impulsor del programa Daniel Czyz.
El Banco Mundial estimó que el impacto económico de esta amenaza podría alcanzar un billón de dólares adicionales en costos de atención médica hacia 2050.
◄ Fotografía de archivo. EFE/Chema Moya
los cuales no son efectivos", afirmó Nadar.
En este programa, los alumnos reciben durante una semana nociones teóricas, realizan experimentos en el laboratorio y exploran posibles soluciones frente a las superbacterias como la inmunoterapia, que estimula al
propio sistema inmunitario; el empleo de bacteriófagos, virus que atacan bacterias, o el desarrollo de nanopartículas con fines terapéuticos.
Los resultados de la prueba piloto de la iniciativa, publicados en la revista Journal of Microbiology & Biology Education, mostraron un au-
El siguiente paso de los investigadores es ampliar el programa a distintas escuelas públicas de Florida, con la esperanza de que pueda incorporarse al currículo estatal y, eventualmente, a nivel nacional.
Para Czyz, la experiencia demuestra que "la educación puede ser una herramienta poderosa en la lucha contra la resistencia a los antimicrobianos".
Juntos podemos® ... Construir comunidades más fuertes y sanas. Causar un impacto en las vidas de las personas a quienes atendemos.
Mejorar la salud. Infundir humanidad. Inspirar esperanza.



Washington, EFE
El presidente de Estados Unidos, Donald Trump, pidió este miércoles a los ganaderos estadounidenses que bajen sus precios en medio de la polémica por su propuesta de importar carne de res de Argentina para reducir el coste de la carne estadounidense, lo que ha provocado rechazo entre los productores.
"Los ganaderos, a quienes quiero mucho, no entienden que la única razón por la que les está yendo tan bien, por primera vez en décadas, es porque impuse aranceles al ganado que ingresa a Estados Unidos", escribió en su red social Truth Social.
"Estaría bien que entendieran eso, pero también de-
ben bajar sus precios, porque el consumidor es un factor muy importante en mi manera de pensar", añadió. El mandatario aseguró en otro mensaje que su guerra comercial "salvó" a los ganaderos estadounidenses.
Hace unos días, el republicano sugirió que EE.UU. comprará carne de res a Argentina para contener la inflación y reducir los altos precios que este producto está alcanzando en el país norteamericano.
Además, reconoció que de esta manera ayudarían al país austral, al que considera un "muy buen aliado" y con el que ha firmado un acuerdo económico por valor de 20.000 millones de dólares para ayudar a su economía.
Sin embargo, esta propuesta no ha sido bien recibida por los ganaderos del país. La Asociación Nacional de Ganaderos (NCBA, por sus siglas en inglés), rechazó este martes la idea de Trump y le pidió que dejara de "intervenir" en el mercado.
"Hacemos un llamamiento al presidente Trump y a los miembros del Congreso para que dejen que el mercado funcione, en lugar de intervenir de formas que no hacen más que perjudicar a las zonas rurales de Estados Unidos", pidió la NCBA en un comunicado.
El director ejecutivo de la asociación, Colin Woodall, aseguró que el plan "solo crea caos" y que no aporta nada para reducir los precios de la carne de res en EE.UU.
"Los ganaderos, a quienes quiero mucho, no entienden que la única razón por la que les está yendo tan bien, por primera vez en décadas, es porque impuse aranceles al ganado que ingresa a Estados Unidos", escribió en su red social Truth Social.
◄ EFE/EPA/ALLISON ROBBERT
Woodall añadió que Argentina tiene una relación comercial "profundamente desequilibrada" con Estados Unidos y destacó las diferencias en las ventas de carne del otro país en cada uno de ellos, así como los "antecedentes de fiebre aftosa".
"Si se introdujera en Estados Unidos, podría devastar nuestra producción ganadera nacional", indicó.
La asociación reconoció que los precios han aumentado, pero defendió que la demanda de los consumidores "sigue siendo fuerte gracias al trabajo realizado por los ganaderos estadounidenses para mejorar la calidad y la seguridad de la carne de res de EE. UU.".

BIENES RAICES

Maria C. Saucedo-Salas Realtor
Maria, vendí mi casa y tengo 60 días para salirme, ¿Debería mantener el seguro de casa puesto, aunque ya no somos dueños de la casa?
En muchos casos, se negocia que el vendedor se puede quedar ocupando la casa ciertos días después de que cierre el trato de su casa. En estos casos, la pregunta es, quien será responsable de mantener seguro si algo sucede durante este tiempo. Si usted va a seguir viviendo y haciéndose responsable de su casa, sería bueno que se proteja. El nuevo dueño de la casa pondrá seguro para la estructura para la vivienda y responsabilidad civil, pero usted deberá mantener algún seguro de renta por si algo le sucede a sus pertenencias de adentro. El seguro de la propiedad puesto por el nuevo dueño asegura la estructura, contra demandas civiles y contra perdida de propiedad personal del nuevo dueño, pero no asegura las pertenencias de usted. Por eso, si va a ocupar la propiedad después del cierre, ponga seguro de renta para proteger sus pertenencias. Por qué debería mantener el seguro
Protección contra riesgos: Mientras aún reside en la propiedad y durante el periodo de aviso, es crucial tener cobertura contra incendios, robos, vandalismo, desastres naturales y otros daños.
Evita la pérdida de cobertura: Si su casa queda vacía durante un período significativo, su póliza normal puede volverse inútil y podría no estar cubierto si ocurre algún incidente.
Prevención de daños: Un seguro puede cubrir gastos inesperados de reparaciones de plomería, daños por tormentas, y otros problemas que puedan surgir.
Para hacer una cita con Maria puede llenar el siguiente formulario, escaneando el código QR al final de esta column.
Llame a Maria ahora para una consulta gratis 616-808-7586 o 248-90-MARIA. Si desea ayuda en comprar o vender su casa, favor de llamar. Si busca información gratis, favor de enviarme su dirección y le mandare un paquete de información gratis. SI NO TIENE CREDITO, LE PODEMOS AYUDAR A COMENZARLO.
OTROS SERVICIOS QUE OFRECEMOS:
• Garantía de Casa Gratis con Compra
• Venta de propiedades
• Compra de Propiedad (Cash)
• Calificación Gratis y Calificación Rápida
• Servicio al Cliente después de compra
• Citas por Zoom
• Notario Público,
• Generador de crédito (para personas que no tienen crédito)
• Visite Facebook.com/maria.saucedo.realtor Para obtener el link y ganar premios
• Si no tiene crédito establecido, debe de tener 3 cuentas a su nombre y le podemos su crédito (renta, luz, gas, celular)


La oficina dental Burton Dental Associates, ubicada en el 2013 de la Eastcastle Dr. SE, al este de la esquina de la Calle 44th y la avenida Kalamazoo en Grand Rapids, es una práctica dental con una trayectoria de 24 años sirviendo a la comunidad del Oeste de Michigan.
Cuenta con un personal entrenado en la odontología, entre ellos varios empleados que hablan español para atender a las necesidades únicas de sus pacientes.
La Dra. Aretha Yamusah, quien nació en el país de Alemania, creció en la parte norte de África, viviendo durante 24 años en la Ciudad de Nueva York y es muy apasionada sobre el servicio de alta calidad que le proveyó a sus clientes. La mujer profesional dice no creer en "un modelo único de odontología para todos".
La práctica dental realiza todo tipo de cuidado dental, entre otros, limpiezas, blanqueamientos, coronas, dentaduras, extracciones, cirugía oral, puentes, rellenos de caries, tratamiento endodóntico, tratamiento para apnea de sueño, ortodoncia y atención dental para personas con necesidades especiales (los llevan al hospital para que puedan realizar los procedimientos de los dientes en un ambiente más seguro y cómodo.
En su página de Internet, el negocio utiliza el lema "La vida se trata de sonrisas", habló sobre el servicio del blanqueamiento dental que ofrecen ($400 por el paquete completo), lo que restaura de manera eficaz la sonrisa de las personas con dientes manchados, sin brillo o descoloridos.
"Una sonrisa ganadora mejorará de inmediato su apariencia, aumentará su confianza y autoestima, lucirá más atractivo y accesible, y cambiará la forma en que otros interactúen con usted", manifiesta la Dra. Yamusah. "El blanqueamiento dental también crea una primera impresión positiva durante entrevistas de empleo y cómo te perciben las personas", agrega.
Durante una Consulta Cosmética de Cortesía, incluirá una visita de 15 minutos con la dentista, una evaluación de sonrisa, las metas que desea para su sonrisa, un examen visual, fotografías digitales, recibirá respuestas a todas sus preguntas y un plan de tratamiento por escrito.
Manifiesta que el blanqueamiento dental se aplica en cuatro incrementos de 15 minutos cada uno, que se puede realizar en una sola visita. Recomienda que el paciente consiga la pasta de dientes florida que les recetan antes de realizar el procedimiento.
El consultorio también tomará una cubeta de impresión de los dientes del paciente para que puedan crear una cubeta de blanqueamiento que el paciente luego se puede llevar a su casa y donde puede continuar el proceso de blanqueamiento dental ahí.
Dijo que el seguro no cubre el blanqueamiento dental, ya que se considera un proceso cosmético. La dentista y su equipo profesional, desean ayudarle a iluminar su sonrisa con un

blanqueamiento dental profesional realizado en la oficina.
"El paciente definitivamente notará una diferencia en el tono de sus dientes después de realizarse el procedimiento", dice la dentista. "Somos una oficina dental enfocada en la familia. "Estamos aquí para servir. Nuestra meta es ayudar a la comunidad", resalta.
Si siempre ha deseado una sonrisa ganadora y maravillosa y le gustaría más información sobre el blanqueamiento dental, comuníquese con la oficina Burton Dental Associates al (616) 455-9900.
▲ La Dra. Aretha Yamusah, propietaria de la práctica dental Burton Dental Associates, ubicada en el 2013 de la Eastcastle Dr. SE, al este de la esquina de la Calle 44th y la avenida Kalamazoo en Grand Rapids. (Foto: Joel Morales para El Informador)
► La dentista Aretha Yamusah (centro), con parte de su equipo, de izq. a der., Stepahie Covington (coordinadora de hospital) y higienistas Elizabeth Rico y Kali Flood. (Foto: Joel Morales para El Informador)




"Una sonrisa ganadora mejorará de inmediato su apariencia, aumentará su confianza y autoestima, lucirá más atractivo y accesible, y cambiará la forma en que otros interactúen con usted. El blanqueamiento dental también crea una primera impresión positiva durante entrevistas de empleo y cómo te perciben las personas", manifiesta la Dra. Yamusah
Los Ángeles, EFE

Mariah Carey ha sido nombrada Persona del Año 2026 por MusiCares, en reconocimiento a su destacada trayectoria artística y su labor filantrópica, informó este martes la Academia de la Grabación.
La cantante recibirá el homenaje durante la 35ª gala que se celebrará dos días antes de los premios Grammy, en el Centro de Convenciones de Los Ángeles.
"La influencia de Mariah Carey va mucho más allá de su extraordinario talento artístico. Ha utilizado su plataforma constantemente para brindar apoyo tangible a las comunidades, ya sea a través de ayuda en caso de desastre, empoderamiento juvenil o programas que ayudan a quienes enfrentan barreras para acceder a oportunidades", expresó Theresa Wolters, directora ejecutiva de MusiCares en un comunicado.
"Honrarla como Persona del Año celebra tanto su increíble legado musical como su dedicación a marcar una diferencia", añadió la directora.
Entre la obra filantrópica que se destaca de Carey, se encuentra el apoyo que brindó a las comunidades afectadas por el huracán Katrina y la pandemia de COVID-19. Además de la fundación de Camp Mariah, en colaboración con Fresh Air Fund, que ayuda a jóvenes desfavorecidos.
La gala Persona del Año tuvo su primera edición en 1991 y se encarga de recaudar fondos para apoyar los programas de MusiCares, incluyendo servicios de salud y bienestar, recuperación de adicciones, atención preventiva, ayuda en caso de desastre y apoyo de emergencia para profesionales de la música.
Carey se unirá el viernes 30 de enero de 2026 a una lista de homenajeados entre los que se incluyen artistas como Joni Mitchell, Jon Bon Jovi o Grateful Dead.
El más reciente lanzamiento de la diva del pop es 'Here For It All', su decimosexto álbum de estudio. Se trata de una producción ecléctica de ritmos como R&B, hip-hop, disco, o gospel.
"La influencia de Mariah Carey va mucho más allá de su extraordinario talento artístico. Ha utilizado su plataforma constantemente para brindar apoyo tangible a las comunidades, ya sea a través de ayuda en caso de desastre, empoderamiento juvenil o programas que ayudan a quienes enfrentan barreras para acceder a oportunidades. Honrarla como Persona del Año celebra tanto su increíble legado musical como su dedicación a marcar una diferencia", expresó Theresa Wolters, directora ejecutiva de MusiCares en un comunicado.
Ciudad de México, EFE
Con su próximo álbum ‘Femme Fatale’, la cantante chilena Mon Laferte, nominada a dos Latin Grammy 2025, se muestra de forma “directa, cruda y real”, explorando la figura de una mujer “libre y peligrosa”, que abraza su “vulnerabilidad y caos interior”, según compartió este miércoles en una conferencia de prensa en Ciudad de México.
Para la cantautora, el término “femme fatale”, surgido en la década de 1950, tiene dos lecturas: la mujer glamourosa que sufre por amor, y la que es libre y peligrosa para los hombres y la sociedad.
Ambas versiones están presentes en su nuevo disco, que se estrena este jueves 23 de octubre, aunque la artista reconoció que se identifica más con la segunda.

una conferencia de prensa este miércoles, en Ciudad de México (México). EFE
“Soy una femme fatale porque pues soy libre y a veces los hombres me temen, como dice la canción ‘La tirana’”, compartió entre risas, respecto a uno de los temas del álbum, en colaboración con la argentina Naty Peluso. No obstante, Laferte describió el disco como “directo, crudo y real”, donde también hay canciones “que le hacen guiños” a la otra mujer fatal, quien “sufre y tiene un poco de caos en su vida”.
El álbum está compuesto por 14 canciones en las que el pop alternativo y el jazz se entrelazan, para crear un universo sonoro “único” que mezcla lo clásico con lo experimental. La artista destacó además como una novedad la exploración del jazz en el disco, así como una colaboración con las mexicanas Natalia Lafourcade y Silvana Estrada.
COMPROMISO CON LA 'LIBERTAD' DE LAS MUJERES Laferte confesó que pensó que ya no la volverían a invitar a los Latin Grammy, después de que en los premios de 2019 se manifestó con un pañuelo verde y ‘topless’ a favor del aborto legal en Chile.
“Pero sí me siguieron invitando, y eso habla del compromiso de la Academia con la música, me encanta, y con la libertad de expresión”, comentó.
La artista, quien ya cuenta con cinco Latin Grammy, llegará el 13 de noviembre próximo a la edición 26 de los premios, con dos nominaciones: Canción del Año por ‘Otra noche de llorar’ y Mejor Video Musical Versión Larga por el documental ‘Mon Laferte, te amo’. Además, expresó que “su compromiso” de luchar por el derecho de las mujeres a decidir si quieren ser madres “sigue ahí”.
“Mi cabeza sigue siendo la misma. De hecho, acabo de estar en Chile, estuve hace unos días y fui a una actividad para hacer conciencia sobre el aborto libre”, contó. Para Laferte, la “libertad” es la principal característica de las ‘femme fatale’, quienes décadas atrás eran vistas como “mujeres muy peligrosas porque eran libres, independientes, no tenían que casarse, fumaban en una mesa”. “Y me encanta eso, por eso también quise ponerle el nombre al disco así. A lo mejor en el futuro van a mirar atrás y van a decir: ‘Antes las mujeres malas (fatales), abortaban’”, expresó.
Velocidad, innovación y algo de frustración
Roger Rivero
Un Volvo EX30, que además de ser el más reciente modelo eléctrico del fabricante sueco, es a la vez el más distanciado de la concepción tradicional de los automóviles. Sé que exagero un poco (y me gusta hacerlo), pero creo que sabemos que estamos en presencia de un automóvil porque lo aparenta por fuera. Tiene cuatro neumáticos, un volante y dos pedales, uno para acelerar y el otro para frenar. El resto es innovación y en muchos casos frustración, pues por ser el modelo más pequeño del fabricante, han sido muy creativos para optimizar el espacio y tratar de mantenerlo económico, llevando el tradicional minimalismo sueco al extremo. Evaluamos esta semana un Volvo EX30 Twin Performance Ultra, el SUV eléctrico compacto más rápido que Volvo ha construido jamás, y una de las primeras víctimas de la guerra de tarifas desatada por la nueva administración estadounidense.
¿QUÉ HAY DE NUEVO?
El EX30 es nuevo en la alineación de Volvo. Aunque se esperaba como modelo 2024, Volvo retrasó su llegada y ahora solo está entregando el modelo Twin Motor o de doble motor en Estados Unidos, donde aún no llega la versión más económica de un solo motor.
¿CÓMO SE VE DESDE AFUERA?
Si pudiera resumir en un solo adjetivo mi impresión del EX30, diría que es “simpático” Volvo marca el tono de su enfoque minimalista con un frontal sin rejilla, aunque sí presenta una versión en relieve de la característica banda de Volvo, que naturalmente interseca su emblema.
El Volvo EX30 tiene el mismo aspecto premium que los otros SUV eléctricos del fabricante, pero mirado de perfil, expone sus dimensiones pequeñas, aunque fornidas, que son parecidas a las de un hatchback compacto. Las ruedas de radio anchas de dos colores y el techo de color contrastante crean una postura fantástica y un aspecto limpio y moderno.
No podían faltar las distintivas luces diurnas “Martillo de Thor” y la forma en que las luces traseras se extienden hasta el techo, pero aquí las llevan a un nivel nuevo y más moderno.
¿Y POR DENTRO?
El interior es puro minimalismo sueco en esteroides. En el EX30 utiliza materiales reciclados para una huella ecológica más sostenible. Una opción de tapicería, por ejemplo, utiliza residuos del proceso de reciclaje de telas mezclilla, mientras que otras opciones incluyen un interior cosido con lino y una alternativa de lana hecha de poliéster reciclado. El compacto EX30 parece mucho más espacioso de lo que sugiere su tamaño. Si bien los asientos traseros están ajustados,

al frente encontramos mucho espacio que utilizan de forma creativa con soluciones de almacenamiento muy escandinavas, como la consola central que se desliza hacia fuera cuando se necesita uno o ambos portavasos, o un pequeño contenedor de almacenamiento extraíble para los asientos traseros.
El espacio de almacenamiento también es bastante bueno para un auto pequeño, con un maletero plano de 12,4 pies cúbicos o 322 litros que se complementan con un maletero delantero más chico, ideal para objetos mojados o una pequeña bolsa de viaje.
Otro elemento clave del diseño interior es el enorme techo corredizo panorámico. Impresiona tanto por dentro como por fuera, pero la falta de un toldo o telón para cerrarlo puede que derive en un problema en días muy calurosos.
TECNOLOGÍA Y SEGURIDAD
Volvo ha seguido la senda de Tesla, concentrando casi todas las funciones en una sola pantalla vertical de 12,3 pulgadas o 31 centímetros, que sirve tanto de infoentretenimiento como de pantalla de indicadores para el conductor. Desde esa pantalla donde la mayoría de los gráficos son diminutos y no muy bien diseñados, se controlan todas las funciones de clima y audio, ajustes de conducción como el manejo con un solo pedal, la posición de los espejos retrovisores y hasta abrir la guantera.
Tras el volante solo encontramos una barra de sensores para rastrear los ojos y la cara del conductor para alertarnos si no mantenemos la vista en la carretera, algo que sucede con frecuencia, mientras buscamos opciones en la omnipresente pantalla, donde también se encuentra el tacómetro para saber la velocidad a la que conducimos.
Los únicos controles físicos presentes están apiñados en el volante, y solo sirven para seleccionar funciones y opciones de menú. Tampoco hay un botón para inicializar el sistema de propulsión eléctrica. Una vez sentados al volante, para activar el EX30, simplemente presionamos el pedal del freno y accionamos la palanca de cambios.
Lo interesante y algo desconcertante es que cuando llegamos a nuestro destino, al salir del auto al no existir botón de apagado o encendido, el audio continúa prendido hasta que nos alejamos y el EX30 se bloquea.
Si padeces como yo del mal de la distracción y dejas las llaves olvidadas dentro del auto, puedes alejarte y no recibirás ninguna señal de alarma, por lo que el radio sigue tocando música a todo volumen. Si algún curioso con malas intenciones se da cuenta, puede que el nuevo Volvo EX30 cambie de dueño en un abrir y cerrar de ojos.
¿CÓMO SE CONDUCE?
Cualquier desavenencia que la frustrante tecnología del EX30 pueda causar, se disipa al ponerlo en marcha. Este es uno de los autos más veloces que he probado, capaz de alcanzar las 60 millas o 100 kilómetros en solo 3,3 segundos.
Se siente perfectamente cómodo y maniobrable al conducir por la ciudad con la dirección ligera, haciendo que sea muy fácil circular entre el tráfico pesado. Trae la función de conducción con un solo pedal, pero, como adivinará usted, para activarla es necesario navegar por la pantalla táctil.
El modelo base de largo alcance y más asequible con un solo motor y tracción trasera no está disponible en Estados Unidos, por lo que aquí solo tenemos la variante más cara de doble motor y tracción total. Por ser fabricado en China, este Volvo es víctima de la guerra de tarifas que ya es parte de nuestro día a día.
La autonomía estimada con doble motor es de 265 millas o 426 kilómetros, lo que está en línea con otros vehículos eléctricos con una batería inferior a 70 kWh, pero en nuestra prueba el EX30 rindió menos, debido al pesado uso del acelerador que hice para disfrutar de los 422 caballos de potencia en un auto pequeño. La estimación de carga rápida de CC es de unos 27 minutos para llevar la batería de 10 % al 80 %.
SI QUIERO UNO, ¿POR CUÁL ME DECIDO?
El Volvo EX30 del 2025 ofrece versiones de uno o dos motores, pero, como antes apuntamos, a esta parte del mundo solo ha llegado la versión más cara y potente de dos motores, equipada con los acabados Plus o Ultra, con precio entre $44,900 y $46,600 dólares.
¿CONTRA QUIÉN COMPITE?
Aunque ya hay una buena variedad de SUV eléctricos, no hay muchos de este tamaño, quizá solo el Mini Countryman eléctrico. Podríamos incluir al Ford Mustang Mach-E, Hyundai Ioniq 5 o el Chevrolet Equinox, todos eléctricos.




¿Y DOLORES DE CABEZA?
Por ser un modelo completamente nuevo, no hay información confiable sobre su predecible confiabilidad; sin embargo, Consumer Report presagia que será menos fiable que el promedio de modelos nuevos, basándose en la historia de otros autos de Volvo.
CONCLUYENDO
Los consumidores necesitan opciones más económicas en el mercado de los automóviles eléctricos y el Volvo EX30 de 2025 es un intento en esa dirección. Es un vehículo eléctrico económico, no uno barato, bien diseñado y construido con gusto, ideal para gente joven que no se frustren por sentirse conectados permanentemente a una pantalla táctil.
Ciudad de México, EFE
La presidenta de México, Claudia Sheinbaum, expresó este jueves su rechazo a los ataques de Estados Unidos contra embarcaciones presuntamente involucradas en el tráfico de drogas fuera de su territorio y reafirmó que México actuará siempre conforme al derecho internacional y la defensa de su soberanía.
“Obviamente nosotros no estamos de acuerdo”, afirmó la mandataria durante su conferencia de prensa matutina al ser consultada sobre las recientes acciones militares de las fuerzas estadounidenses en aguas internacionales.
“Hay leyes internacionales de cómo tiene que operarse frente a un presunto transporte de droga o de armas en aguas internacionales, y así lo hemos manifestado al Gobierno de Estados Unidos

marco constitucional en esta materia.
“Incluso modificamos la Constitución para fortalecer el sentido de soberanía en el artículo 40, frente a cualquier intervencionismo o injerencismo”, añadió.
La reacción de la gobernante mexicana ocurre luego de que la Administración del presidente estadounidense, Donald Trump, ampliara sus operaciones militares contra el narcotráfico con al menos dos ataques a embarcaciones en el Pacífico, cerca de Colombia, que supuestamente transportaban drogas, tras los realizados anteriormente contra supuestas narcolanchas en el Caribe, cerca de Venezuela.
Por otro lado, la presidenta mexicana evitó pronunciarse directamente sobre los recientes intercambios de declaraciones entre Trump y el prey públicamente”, subrayó. La gobernante mexicana enfatizó que su Administración mantiene un diálogo franco
con Washington, pero “sin renunciar nunca a nuestros principios de soberanía, libre determinación y auto -
determinación del pueblo de México”.
Sheinbaum recordó que su Gobierno ha fortalecido el
sidente de Colombia, Gustavo Petro, pero llamó a mantener el respeto diplomático.
“Cada quien tiene sus formas de enfrentar algún debate internacional o la relación con Estados Unidos”, señaló. Con un tono conciliador, la presidenta reiteró que su política exterior se guía por los principios históricos de México, combinando la firmeza en la defensa de la soberanía con la cooperación internacional.
“Nosotros hemos establecido ese mecanismo”, insistió. El Gobierno mexicano ha reiterado en diversas ocasiones que cualquier acción fuera del marco legal internacional puede poner en riesgo la cooperación bilateral en materia de seguridad, en el marco de la colaboración entre México y Estados Unidos para combatir el crimen organizado y atender las causas sociales del narcotráfico.

Necesitamos trabajadores con experiencia en la demolición de interior, de $18 a $20 por hora. Aumentos rápidos y beneficios.
PRESENTAR IDENTIFICACIÓN CON FOTOGRAFÍA O LICENCIA DE MANEJO
Aplica en Walch Construction 1035 BUTTERWORTH SW, Grand Rapids, MI, 49508
CONTACTO KEN: 616-458-7781


¿QUIERES RECIBIR LAS NOTICIAS DE ÚLTIMA HORA? MANDANOS UN MENSAJE AL 616 264 2708 Y TE AGREGAMOS AUTOMÁTICAMENTE

Redacción Deportes, EFE
Por segundo año consecutivo y con una barrida de cuatro victorias en igual número de salidas, los Dodgers de Los Angeles se clasificaron este viernes a la Serie Mundial a expensas de los Cerveceros de Milwaukee.
Los flamantes campeones de la Liga Nacional buscarán desde el 24 de octubre el bicampeonato del Clásico de Otoño ante el ganador de la serie entre los Marineros de Seattle y los Azulejos de Toronto, que van ganando los primeros por 3-2.
Como en los anteriores tres juegos, la novena angelina hoy no dio margen de reacción a sus rivales, a los que derrotaron por 5-1 en el Dodger Stadium con un auténtico recital del japonés Shohei Ohtani, que impulsó tres cuadrangulares.
DODGERS 5-1
CERVECEROS
Ohtani, quien fue escogido Jugador Más Valioso de la Serie de Campeonato, despachó la pelota por encima de la pared del jardín derecho ante los envíos del colombiano José Quintana.
Volvió al ataque en el cuarto episodio con otro cuadrangular ante la impotencia del relevista Chad Patrick. Y repitió el logro en el séptimo acto ante la mirada de Trevor Megill desde la lomita.
Con sus tres jonrones, Ohtani es el duodécimo que lo hace en un juego de postemporada en la historia de las Grandes Ligas. Entre otros ya lo lograron el puertorriqueño Kiké Hernández, los dominicanos Albert Pujols y Adrián Beltré y los venezolanos José Altuve y Pablo Sandoval.
Desde el montículo, Ohtani trabajó seis entradas en las que apenas permitió tres imparables, otorgó tres bases por bolas y ponchó a 10.
Los Dodgers limitaron a los Cerveceros a solo cuatro carreras en los cuatro juegos de la serie al mejor de siete.

El lanzador estelar de los los Dodgers de Los Angeles, Shohei Ohtani (c) celebra el jonrón, el tercero, impulsado este viernes durante el cuarto juego de la Serie de Campeonato de la Liga Nacional que anticipó su paso a la Serie Mundial con barrida plena (4-0) a los Cerveceros de Milwaukee. EFE/EPA
Quintana (0-1) permitió tres carreras en dos entradas y perdió el juego por los Cerveceros.
MARINEROS 6-2
AZULEJOS
El venezolano Eugenio Suárez disparó dos cuadrangulares, entre ellos un grand slam, y remolcó cinco carreras en la exhibición de los Marineros, que dominan el pulso por 3-2 y quedaron a un triunfo más para conquistar el Campeonato de la Liga Americana y sellar de paso su visado para la Serie Mundial. Suárez pegó un vuelacercas en la segunda entrada para inaugurar el marcador y luego fletó su grand slam, productor de cuatro carreras que rompió el empate en la octava entrada del juego en el T-Mobile Park de Seattle. Antes del batazo ganador de Suárez, Cal Raleigh mandó la pelota fuera del parque para igualar el marcador por los Marineros.
El cubano Randy Arozarena, quien anotó una carrera por los de Seattle, le robó lo que sería un cuadrangular a Ernie Clement en la parte alta del octavo capítulo, saltando y tomando la pelota que se dirigía a superar la pared del jardín izquierdo.

El lanzador abridor de los Los Angeles Dodgers, Shohei Ohtani, conecta uno de los tres jonrones en el cuarto juego de la serie que ganaron este viernes por barrida (4-0) a los Cerveceros de Milwaukee y que proporcionó a la novena angelina el título de la Liga Nacional y el pase a la Serie Mundial por segundo año consecutivo. EFE/EPA

Los Marineros de Seattle celebran este viernes la victoria sobre los Azulejos de Toronto que deja la serie 3-2 a su favor, a una victoria más para imponerse en la Serie de Campeonato de la Liga Americana y anticpar la presencia en la Serie Mundial. EFE/EPA/JOHN G. MABANGLO
Gabe Speier (1-0) tiró un capítulo en blanco para acreditarse la victoria por los Marineros.
La derrota fue para Brendon Little (0-1), quien permitió tres anotaciones, sin retirar a

El mediocentro colombiano Richard Ríos se queja de una falta fuerte durante el partido amistoso con la selección de Canadá que terminó empatado 0-0 este martes en el estadio Red Bull Arena, en Nueva Jersey. EFE/ Ángel Colmenares
Redacción Deportes, EFE
Las selecciones de Colombia y Canadá no se hicieron daño este martes e igualaron 0-0 en un partido amistoso jugado en el Sports Illustrated Stadium del pueblo estadounidense de Harrison (Nueva Jersey), donde hubo pocas emociones y mucho juego fuerte. Los suramericanos, dirigidos por el argentino Néstor Lorenzo, aprovecharon para probar a varios jugadores y el experimento no le dio muy buen resultado al estratega, pues el equipo tuvo dificultades para crear peligro y asociarse bien.
Sin embargo, los canadienses tampoco hicieron mucho daño en ataque y ambos equipos le quedaron debiendo emociones a la multitud que llegó hasta el Sports Illustrated Stadium.
Los norteamericanos impusieron condiciones en los primeros minutos con la presión alta que ejercieron sobre la salida de los cafeteros, que tuvieron muchas dificultades para hilvanar secuencias de pases e hicieron llegar muy pocos balones al goleador Juan Camilo 'Cucho' Hernández.
El equipo de Jesse Marsch empezó a asociarse principalmente por el costado derecho, donde el volante Tajon Buchanan se convirtió en un dolor de cabeza para la defensa por su movilidad.
No obstante, la presión alta y el trabajo de Buchanan no tuvieron efectos positivos en los ataques, pues pesaron poco los delanteros Jonathan David y Tani Oluwaseyi, completamente controlados por los centrales colombianos Jhon Lucumí y Davinson Sánchez.
Las imprecisiones y el juego brusco marcaron el ritmo de un primer tiempo en el que ninguno de los dos equipos tuvo oportunidades claras de anotar y los porteros Álvaro Montero y Dayne St. Clair.
En el segundo tiempo, el seleccionador de Colombia, Néstor Lorenzo, dio ingreso a James Rodríguez para tratar de tener más el balón, pero su equipo aún tuvo muchas dificultades para crear oportunidades.
Con el paso de los minutos, tanto los norteamericanos como los cafeteros se relajaron y empezaron a dejar espacios.
ninguno de los bateadores que enfrentó.
Los Marineros y los Azulejos se enfrentarán el próximo domingo en el sexto partido de la serie, que se jugará en el Rogers Centre de Toronto.
Así fue como llegó la primera oportunidad clara del partido al 56 en un contragolpe letal liderado por Cucho Hernández, que habilitó a Luis Díaz que en el mano a mano sacó un derechazo que pasó rozando el palo izquierdo de St. Clair.
Canadá, por su parte, siguió haciendo daño por la derecha con Buchanan y empezaron a aparecer más David y Oluwaseyi, aunque tampoco estuvieron del todo claros y fueron controlados por una organizada defensa colombiana. ►P.31

Redacción Deportes, EFE
Racing Club y Liga de Quito emprenderán esta semana la difícil misión de comenzar a sacar a Flamengo y Palmeiras de la autopista que conduce a la final de la Copa Libertadores y poner fin de paso a una hegemonía brasileña en el torneo que se instaló en 2019, hace ya seis temporadas. Desde entonces, y hasta 2024, cuatro equipos brasileños conquistaron las seis finales disputadas. Flamengo, rival desde este martes del Racing Club argentino, se alzó con los títulos
de 2019 y 2022. Y Palmeiras, que desde este miércoles tendrá como rival en semifinales a Liga de Quito, conquistó las ediciones de 2020 y 2021.
Pero brasileños fueron también los que celebraron en 2023 y 2024. Primero fue Fluminense y el año pasado le llegó el turno a Botafogo.
Tan asfixiante ha sido la supremacía del llamado 'país do futebol' que de las últimas cinco finales, cuatro han sido entre equipos brasileños. En 2020, un año después de coronarse Flamengo a expensas del River Plate
argentino, Palmeiras se impuso al Santos que hizo célebre Pelé. En 2021 Palmeiras volvió a dar la vuelta olímpica tras derrotar a Flamengo.
El mismo equipo rojinegro de Río de Janeiro tuvo su revancha un año después en la decisión que ganó al Athletico Paranaense.
En 2023 otro tradicional club argentino, Boca Juniors, llegó con serias pretensiones a la final, pero nada pudo hacer con Fluminense.
Y el año pasado, la primera Copa Libertadores de Botafogo llegó a sus vitrinas tras derrotar a Atlético Mineiro.


Al minuto 75, cuando había pocas emociones en el partido, David anotó en una jugada muy rápida, pero el juez estadounidense Guido González anuló el gol porque en la jugada previa Jacob Shaffelburg, quien hizo la asistencia, estaba en fuera de juego.
Al final, Rafael Santos Borré tuvo una oportunidad para Colombia y el lateral derecho Andrés Román otra con un remate que se estrelló en el palo, lo que casi hace celebrar a los sudamericanos que llenaron el estadio. Pese a eso, ninguno de los dos equipos le hizo daño al otro y el partido terminó 0-0. - Ficha técnica:
0. Colombia: Álvaro Montero; Andrés Román, Davinson Sánchez, Jhon Lucumí, Johan Mujica; Juan Camilo Portilla (m.79, Jefferson Lerma), Richard Ríos (m.78, Kevin Castaño), Jaminton Campaz (m.46, James Rodríguez), Juan Fernando Quintero (m.60, Kevin Serna); Luis Díaz (m.60, Yasser Asprilla) y Juan Camilo 'Cucho' Hernández (m.60, Rafael Santos Borré).
Seleccionador: Néstor Lorenzo.
0. Canadá: Dayne St. Clair; Niko Sigur (m.84, Zohran Bassong), Luc de Fougerolles, Derek Cornelius, Richie Laryea; Ismaël Koné (m.84, Matthieu Choiniere), Stephen Eustáquio, Tajon Buchanan (m.71, Jacob Shaffelburg), Ali Ahmed (m.60, Liam Millar); Jonathan David y Tani Oluwaseyi (m.72, David Promise).
Seleccionador: Jesse Marsch.
Árbitro: el estadounidense Guido González. Amonestó a Richie Laryea, Derek Cornelius y Niko Sigur.
Incidencias: partido amistoso jugado en el Sports Illustrated Stadium del pueblo estadounidense de Harrison (Nueva Jersey).


